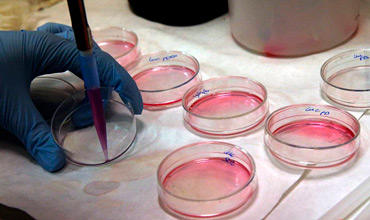
Profesionales en Regulación Sanitaria de Medicamentos y Estupefacientes

Profesionales en Regulación Sanitaria de Medicamentos y Estupefacientes
• Medicamentos Genéricos (Fracciones I, II, III, IV, V y VI).
• Moléculas Nuevas.
• Productos a base de Cannabis y sus Derivados Farmacológicos en Suplementos Alimenticios, Cosméticos, Alimentos, bebidas alcohólicas y no alcohólicas, Remedios Herbolarios, Medicamentos Herbolarios, Medicamentos Controlados, Materia Prima, en cualquiera de sus etapas: Importación, Fabricación, Distribución, Comercialización o Consumo.